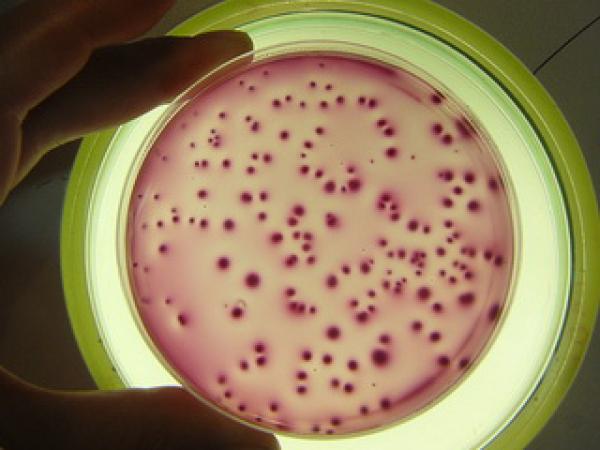

Category: Da li znate


Otkrivena hemikalija koja je ključ sreće

Umesto globalnog zagrevanja sledi nam ledeno doba

Koji disk uzeti – SSD vs SATA 3?

Najmanji telefon na svetu: Kao šibica

Nova teorija: Smrt ne postoji?!

Kanadski glečeri prete Zemlji

Južnokorejski naučnik je izumeo beton koji se sam ‘leči’
Bakterija iz noćne more ubija polovinu zaraženih pacijenata
